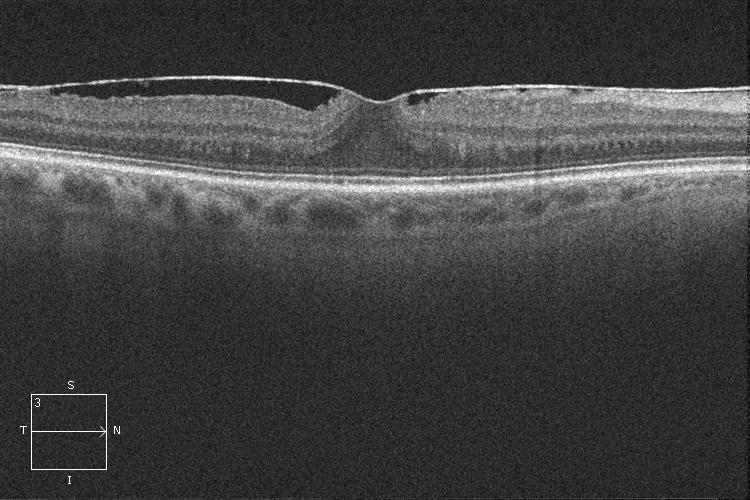
fullwidth image
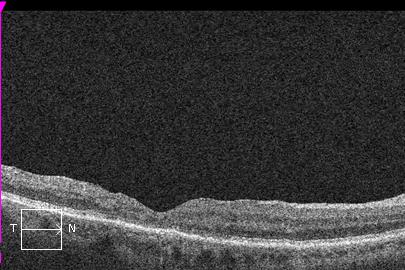
fullwidth image

Membrana epirretiniana macular
¿Qué es una membrana epirretiniana macular?
Es una fina membrana que aparece sobre la retina macular y cuyas propiedades contráctiles hacen que la superficie retiniana se arrugue. Suelen aparecer en pacientes mayores de 60 años y en la mayoría de casos no tienen una causa conocida (Idiopáticas). Algunas veces son secundarias a traumatismos, inflamaciones o cirugías oculares.
¿Qué síntomas produce una membrana epirretiniana macular?
La membrana epirretiniana macular se manifiesta por una pérdida de visión progresiva y la aparición de metamorfopsias (distorsión visual en que las líneas rectas u objetos aparecen ondulados o curvados).
¿Cómo se diagnostica una membrana epirretiniana macular?
La membrana epirretiniana macular se diagnostica mediante un examen del fondo del ojo y la realización de una OCT.

OCT. Membrana epirretiniana
¿Cómo se trata una membrana epirretiniana macular?
El único tratamiento de la membrana epirretiniana macular es la cirugía. Esta debe realizarse cuando existe una pérdida de agudeza visual importante, progresiva o que interfiere en la vida cotidiana del paciente. También está indicada cuando hay distorsión visual (metamorfopsias).
¿En qué consiste la cirugía de la membrana epirretiniana macular?
La cirugía de una membrana epirretiniana macular consiste en realizar una vitrectomía (extracción del humor vítreo) para acceder a la retina y extraer mediante un pelado la membrana. En la mayoría de los casos se consigue una recuperación visual y desaparición de las metamorfopsias. Es una intervención quirúrgica no dolorosa que se hace bajo anestesia local (retrobulbar) y de forma ambulatoria.
OCT. Membrana epirretiniana antes de la cirugía